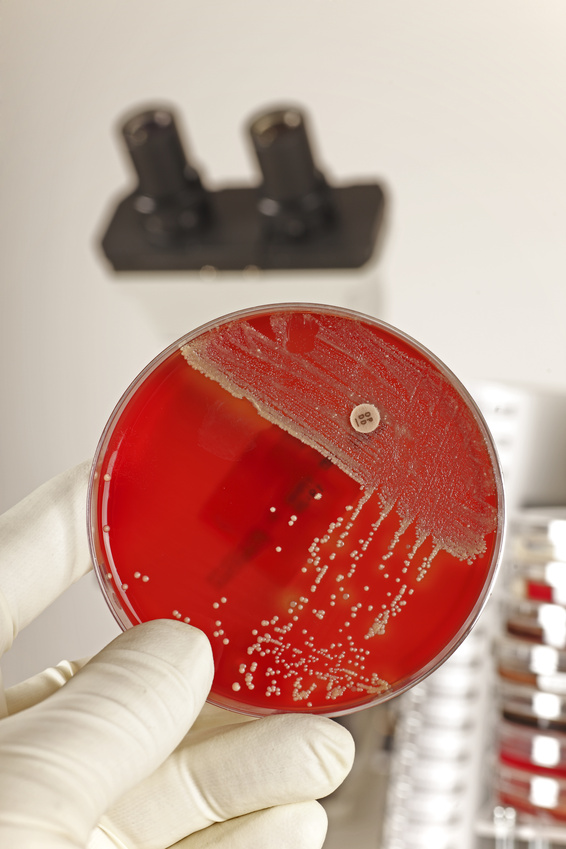

#staphylococcusaureus نتائج البحث
Out Now! Nasal Staphylococcus aureus carriage promotes depressive behaviour in mice via sex hormone degradation bit.ly/46jNlAA #StaphylococcusAureus #DepressionResearch #Microbiology

Natural Remedies for a Staph Infection. The guava fruit consumed regularly and the tea made from the leaves are effective in treating a staph infection. #Staphylococcusaureus #MRSA

📌Welcome to read the highly cited paper on: #Staphylococcusaureus #milk #mastiticcows 🎓By: Mária Vargová, Ibrahim F. Rehan from University of Veterinary Medicine and Pharmacy in Košice, Slovakia and Menoufia National University, Egypt 🔎Read more at: mdpi.com/2306-7381/10/6…

A team of USF researchers hopes to treat severe staph infections by using a simpler and more efficient technique with far less stress to patients than traditional treatment. ow.ly/y4Kb50WGBiC #Dalvance #AntibioticResearch #StaphylococcusAureus #USFResearch
Dat hadden we nog niet gezien. Een #krentenbaard epidemie in Nederland ... #impetigo #StaphylococcusAureus

BiomX's BX211, is a bacteriophage therapy that precisely targets Staphylococcus aureus 🦠—the leading bacterial cause of Diabetic Foot Osteomyelitis. BX211’s targeted approach may speed up healing ⏳ & help prevent amputations 🦵❌ #BiomX #StaphylococcusAureus #WoundHealing #DFO
⏱️ When Every Hour Counts #InfectiousDiseases #Endocarditis #StaphylococcusAureus #Echocardiography @BCMIDFellowship @bcmhouston @CIDJournal
🫀Echo Smarter, Not Harder! Not all S. aureus bacteremia needs echo. Timing of blood culture positivity + PREDICT helps us strike the balance: catching endocarditis, sparing low-risk patients @RizwanSohailMD @bcmhouston @BCMIDFellowship 🔥just out in CID bit.ly/414O99k

Colonization with #staphylococcus is an independent &modifiable risk factor for #periprostheticjointinfections and carriers of #staphylococcusaureus are x10 more likely than non-carriers for postoperative #infections 📄 bit.ly/3tqKfd3 #arthroplasty #PJI #TJA #OpenReviews

🧠 Artículo de Revisión: bacteriemia por #Staphylococcusaureus 📉 Letalidad: 15–30% ⚰️ +300.000 muertes/año 📌 1 de cada 3: infecciones profundas 🧪 Diagnóstico molecular precoz + control del foco 🛠️ + 👨⚕️El infectólogo 📲 Completo en mi Telegram: t.me/infectologias


#Staphylococcusaureus #infection #skin Used salt water for cleaning, magnesium paste, Germolene. Nothing. GP prescribing #Flucloxacillin Interesting my mental health declined last few days too. Similarly to #PANS #PANDAS but symptoms not so extreme.

The @AZinkernagelLab finds that #StaphylococcusAureus tolerates antibiotics through a mechanism involving PknB, which triggers serine-threonine #phosphorylation of bacterial proteins and boosts persistence in acidic conditions. @Unispital_USZ @MarkusH1991 scim.ag/146

Staphylococcus aureus ‘golden staph' is a type of bacteria that can cause bloodstream infection. The national rate of golden staph infection remained below the nationally agreed benchmark in 2022–23. Learn more brnw.ch/21wJRGs #goldenstaph #staphylococcusaureus

Molecular surveillance of daptomycin DAP-resistant #StaphylococcusAureus showed 🔵DAP-Resistance-Acquisition was linked to antiseptic rather than systemic antibiotic wound-treatment 🔵Resistance developed in all affected patients individually @CMIJournal ➡️authors.elsevier.com/a/1hNEB,RGPgSB…
Jack 💙 All Over the World Do send us your own ways of remembering Jack. Thank you. @UniofOxford #raisingawareness #helpingyoungsters #staphylococcusaureus #pericarditis

बरेली के गाय, भैंस और सूअरों में खतरनाक बैक्टीरिया का पता चला है, जो इंसानों के लिए भी बड़ा खतरा बन सकता है। यह बैक्टीरिया कई एंटीबायोटिक्स के प्रति प्रतिरोधी पाया गया है, जिससे इलाज में मुश्किलें आ सकती हैं। gaonjunction.com/pashudhan/icar… #AntibioticResistance #StaphylococcusAureus
gaonjunction.com
डराने वाली रिपोर्ट: बरेली के गाय, भैंस और सूअरों में मिला खतरनाक बैक्टीरिया, इंसानों पर बड़ा खतरा,...
शोधकर्ताओं का कहना है कि यह स्थिति न केवल पशु स्वास्थ्य बल्कि मानव स्वास्थ्य के लिए भी गंभीर खतरा है। अगर एंटीबायोटिक्स
People with eczema are at an increased risk for #StaphylococcusAureus (or “staph”) infections. 💥 Read about #eczema and #staph infections: nationaleczema.org/blog/staph-ecz… #GetEczemaWise #StaphInfection #Staphylococcus #SkinInfection #BacterialInfection #Microbiome #SkinMicrobiome



Check out the poster presentation by #ARLGNetwork member Nicholas A. Turner, MD, MHSc on the DOTS study – dalbavancin for complicated #staphylococcusaureus bacteremia – at #ESCMIDGlobal2024! @DukeAdultID #InfectiousDiseases

Jack 💙 All Over the World 🌍🌏🌎 Balgownie Estate Balgownie, New South Wales, Australia Thank you to Sue Phillips for this beautiful photo. Balgownie Estate Bendigo, Victoria, Australia. Glamping. #raisingawareness #Staphylococcusaureus #pericarditis

#Staphylococcusaureus #vaccine candidate receives #FDA Fast-Track designation open.substack.com/pub/outbreakne…

Out Now! Nasal Staphylococcus aureus carriage promotes depressive behaviour in mice via sex hormone degradation bit.ly/46jNlAA #StaphylococcusAureus #DepressionResearch #Microbiology

बरेली के गाय, भैंस और सूअरों में खतरनाक बैक्टीरिया का पता चला है, जो इंसानों के लिए भी बड़ा खतरा बन सकता है। यह बैक्टीरिया कई एंटीबायोटिक्स के प्रति प्रतिरोधी पाया गया है, जिससे इलाज में मुश्किलें आ सकती हैं। gaonjunction.com/pashudhan/icar… #AntibioticResistance #StaphylococcusAureus
gaonjunction.com
डराने वाली रिपोर्ट: बरेली के गाय, भैंस और सूअरों में मिला खतरनाक बैक्टीरिया, इंसानों पर बड़ा खतरा,...
शोधकर्ताओं का कहना है कि यह स्थिति न केवल पशु स्वास्थ्य बल्कि मानव स्वास्थ्य के लिए भी गंभीर खतरा है। अगर एंटीबायोटिक्स
A team of USF researchers hopes to treat severe staph infections by using a simpler and more efficient technique with far less stress to patients than traditional treatment. ow.ly/y4Kb50WGBiC #Dalvance #AntibioticResearch #StaphylococcusAureus #USFResearch
@PublicHealth @CIDRAP_ASP @ASCLS @APHL Using generative AI, researchers design compounds that can kill drug-resistant bacteria news.mit.edu/2025/using-gen… MIT News Aug 14 2025 Cell Aug 14 2025 cell.com/cell/abstract/… #Neisseriagonorrhoeae #Staphylococcusaureus #MRSA
⏱️ When Every Hour Counts #InfectiousDiseases #Endocarditis #StaphylococcusAureus #Echocardiography @BCMIDFellowship @bcmhouston @CIDJournal
🫀Echo Smarter, Not Harder! Not all S. aureus bacteremia needs echo. Timing of blood culture positivity + PREDICT helps us strike the balance: catching endocarditis, sparing low-risk patients @RizwanSohailMD @bcmhouston @BCMIDFellowship 🔥just out in CID bit.ly/414O99k

📌Welcome to read the highly cited paper on: #Staphylococcusaureus #milk #mastiticcows 🎓By: Mária Vargová, Ibrahim F. Rehan from University of Veterinary Medicine and Pharmacy in Košice, Slovakia and Menoufia National University, Egypt 🔎Read more at: mdpi.com/2306-7381/10/6…

Cardiac Implantable Electronic Device (CIED) #infections are hard to diagnose due to frequent culture-negative cases. Coagulase-Negative Staphylococci (CONS) and #StaphylococcusAureus are common causes. Combined clinical and imaging tools are essential. brieflands.com/articles/ircrj…
This study offers insights into the complex resistance mechanisms of #Staphylococcusaureus to #Novobiocin and highlights the metabolic costs associated with #GyrB mutations, potentially guiding the development of future #antibacterial strategies. #OpenAccess:…

🧪 This study investigates the antibacterial activity of three tricyclic antidepressants against Staphylococcus aureus. Results show bactericidal effects, synergy with oxacillin, and cellular disruption. 🔗: brnw.ch/21wTXVf #StaphylococcusAureus #AMR #Pharmacology

N-Organothio β-Lactams Offer New Opportunities for Controlling Pathogenic Bacteria 🔓Read: brnw.ch/21wTUpi #Pathogens #Bacteria #StaphylococcusAureus #MRSA #ReviewArticle
🧫📷 New Original Research in FBS! Staphylococcus aureus Strains With a Negative Coagulase Tube Test are Associated With Staphylocoagulase Genotypes ✒️ Author: Carly L. Botheras et al. 🔔imrpress.com/journal/FBS/17… #StaphylococcusAureus #Microbiology #InfectiousDiseases

🧠 Artículo de Revisión: bacteriemia por #Staphylococcusaureus 📉 Letalidad: 15–30% ⚰️ +300.000 muertes/año 📌 1 de cada 3: infecciones profundas 🧪 Diagnóstico molecular precoz + control del foco 🛠️ + 👨⚕️El infectólogo 📲 Completo en mi Telegram: t.me/infectologias


How can the parameter NEUT-RI be related to neutrophil activation? Test your knowledge by taking the quiz and view the full case including images here: bit.ly/4mGsygq #ScientificiCalendarCase #StaphylococcusAureus #NEUTRI #bacteraemia #SysmexBNL
#Article in @Mol_Biomed Chemoproteomics unveils Sofalcone targeting ribosomal proteins to inhibit protein synthesis in Staphylococcus aureus Learn more in doi.org/10.1186/s43556… #Sofalcone #StaphylococcusAureus #Chemoproteomics #RibosomalProtein #Antibiotics #DrugResistance

People with eczema are at an increased risk for #StaphylococcusAureus (or “staph”) infections. 💥 Read about #eczema and #staph infections: nationaleczema.org/blog/staph-ecz… #GetEczemaWise #StaphInfection #Staphylococcus #SkinInfection #BacterialInfection #Microbiome #SkinMicrobiome



Out Now! Nasal Staphylococcus aureus carriage promotes depressive behaviour in mice via sex hormone degradation bit.ly/46jNlAA #StaphylococcusAureus #DepressionResearch #Microbiology

Colonization with #staphylococcus is an independent &modifiable risk factor for #periprostheticjointinfections and carriers of #staphylococcusaureus are x10 more likely than non-carriers for postoperative #infections 📄 bit.ly/3tqKfd3 #arthroplasty #PJI #TJA #OpenReviews

The @AZinkernagelLab finds that #StaphylococcusAureus tolerates antibiotics through a mechanism involving PknB, which triggers serine-threonine #phosphorylation of bacterial proteins and boosts persistence in acidic conditions. @Unispital_USZ @MarkusH1991 scim.ag/146

#Staphylococcusaureus #vaccine candidate receives #FDA Fast-Track designation open.substack.com/pub/outbreakne…

Crystal structure of Staphylococcus aureus lipase complex with unsaturated petroselinic acid 👉buff.ly/3wUBOIO #Staphylococcusaureus #Lipase #Crystalstructure #StructuralBiology

People with eczema are at an increased risk for #StaphylococcusAureus (or “staph”) infections. 💥 Read about #eczema and #staph infections: nationaleczema.org/blog/staph-ecz… #GetEczemaWise #StaphInfection #Staphylococcus #SkinInfection #BacterialInfection #Microbiome #SkinMicrobiome



🌟Happening today| ISAC webinar🌟 Antibiotic susceptibility patterns used for epidemiologic surveillance of #Staphylococcusaureus Organised by the ISAC MRSA Working Group 📆11 July 2024 ⏰ 15.00 CET / 09.00 EST Don't miss out - register now⬇️ tinyurl.com/2kk7ttff #MRSA #MSSA

📌#Staphylococcusaureus #sortaseA #moleculardocking #inhibitor #antibioticresistance New Publication “Identification of Novel Antistaphylococcal Hit Compounds Targeting Sortase A” By: Georgiana Nitulescu, et al. 👉mdpi.com/1420-3049/26/2… #mdpimolecules #NewPublication

📚 A novel gyrase inhibitor from toxin–antitoxin system expressed by Staphylococcus aureus ✏️ By Masayori Inouye and team 🔗 buff.ly/3lsd3OC #DNAgyraseinhibitor #secondarystructure #Staphylococcusaureus

Natural Remedies for a Staph Infection. The guava fruit consumed regularly and the tea made from the leaves are effective in treating a staph infection. #Staphylococcusaureus #MRSA

#ACADEMY23: #PseudomonasAeruginosa and #StaphylococcusAureus bacteria, #AcanthamoebaCastellanii, and #MouseHepatitisVirus can adhere to hydrogel and silicone hydrogel daily #DisposableContactLenses. @aaopt Read more: brnw.ch/21wDDI9 #Optometry #ContactLenses #EyeHealth

Staphylococcus aureus ‘golden staph' is a type of bacteria that can cause bloodstream infection. The national rate of golden staph infection remained below the nationally agreed benchmark in 2022–23. Learn more brnw.ch/21wJRGs #goldenstaph #staphylococcusaureus

Check out the poster presentation by #ARLGNetwork member Nicholas A. Turner, MD, MHSc on the DOTS study – dalbavancin for complicated #staphylococcusaureus bacteremia – at #ESCMIDGlobal2024! @DukeAdultID #InfectiousDiseases

#mostcited 🏆Top Cited Review in 2022 Q3 📚Molecular Mechanisms of Drug Resistance in Staphylococcus aureus 🔗mdpi.com/1738502 👨🔬By Dr. Beata Mlynarczyk-Bonikowska et al @MDPIOpenAccess @MDPIBiologySubj #Staphylococcusaureus #drugresistance #microbiology

Dat hadden we nog niet gezien. Een #krentenbaard epidemie in Nederland ... #impetigo #StaphylococcusAureus

AN EVOLUTION born from cycles of GENOCIDE FEMICIDE TRAUMA WAR and TRAGEDY NOT An Accidental Mishap of Black Magic #StaphylococcusAureus @UNHumanRights

Jack 💙 All Over the World Do send us your own ways of remembering Jack. Thank you. @UniofOxford #raisingawareness #helpingyoungsters #staphylococcusaureus #pericarditis

#AntimicrobialSusceptibility of #StaphylococcusAureus (S aureus) for some #Antibiotics may be less than ideal for empirical use in patients with #AtopicDermatitis (AD). Published in @JAMADerm Read here: bit.ly/4f34FeP #Optometry #EyeHealth #MedTwitter

Something went wrong.
Something went wrong.
United States Trends
- 1. Bills 111K posts
- 2. Falcons 30.2K posts
- 3. Josh Allen 13.6K posts
- 4. phil 129K posts
- 5. Bijan 18.8K posts
- 6. Drake London 5,172 posts
- 7. Bears 47.4K posts
- 8. Chris Moore 1,888 posts
- 9. Caleb 32.3K posts
- 10. Freddie 11.4K posts
- 11. #NLCS 6,295 posts
- 12. Dan Quinn 1,068 posts
- 13. McDermott 4,004 posts
- 14. #RaiseHail 5,105 posts
- 15. Matt Gay N/A
- 16. Snell 3,650 posts
- 17. Commanders 31.2K posts
- 18. Jayden 12.1K posts
- 19. Teoscar 1,057 posts
- 20. Beane 2,038 posts